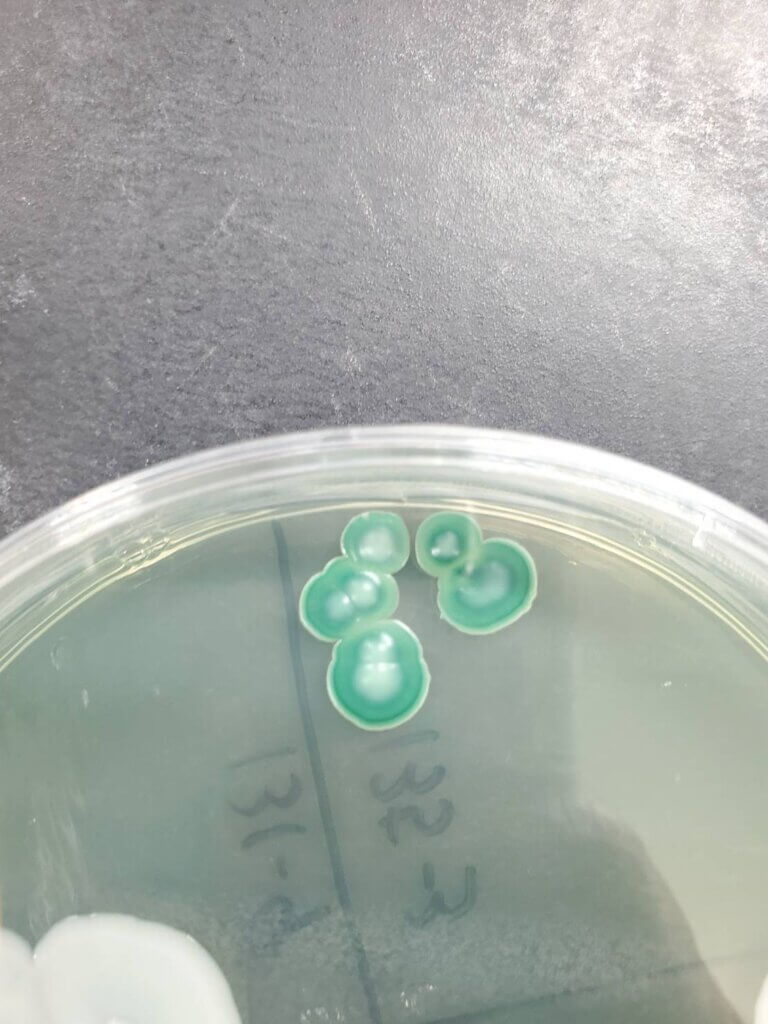

444年の時を超え、再び動き出した歴史の一滴 ― 百済寺樽。
かつて室町時代に朝廷や幕府にも献上された幻の清酒「百済寺樽」。
戦国の動乱で途絶えたその歴史を、現代によみがえらせる挑戦「百済寺樽復活プロジェクト」が2016年より始まりました。

復活から10年。百済寺樽は今、百済寺繁栄の象徴である、信長の焼き討ちを生き抜いた「菩提樹」の酵母で新たな酒造りに挑戦をすることにしました!
今回、普段は立ち入ることのできない滋賀県工業技術総合センターの醸造研究現場を特別に公開。
17株の選抜された優良株を確認し「百済寺樽の次の歴史」の1ページに一緒に立ち会ってくだっさるメンバーを3名限定で募集します!
どんなお酒になっていくのか、プロジェクトのメンバーと一緒に見学してみませんか?
この貴重なプロジェクトの“現場”を体験できる、希少な一般参加枠を限定3名だけ募集します。

1573年、織田信長による焼き討ちで一度は灰燼に帰した百済寺。
この寺は、室町時代に来日したカトリック宣教師ルイス・フロイスにより 「地上の天国」と称された歴史を持つ滋賀県屈指の古刹です。
その境内には、焼き討ちを生き延び、今もなお命をつなぐ一本の菩提樹があります。
生き物の命が輝く、百済寺の象徴とも言える「菩提樹」より酵母を採取し、酒造りに活かしていきます…!



今回はこの菩提樹の花から採取した酵母の研究いただいている 滋賀県工業技術総合センター 様 が 特別に醸造試験の様子を公開。
選抜された百済寺酵母での醸造試験を見学できます!(まだ食品として許可がでていないため試飲はできません。見学のみ。)

こんな人におすすめ
- 地域の歴史や文化を“未来につなぐ”プロジェクトにワクワクする
- 日本酒・発酵・酵母の世界を、研究の現場で見てみたい
- 百済寺樽を知っている/気になっていた(初めてでもOK)
- ものづくりの“裏側”が好き(試験醸造・菌株選抜など)
- プロジェクトの過程を一緒に楽しみ、周囲に広めてくれる方
みどころ
1. 百済寺酵母研究の過程を特別公開
仕込み後約10日、総米200gスケールの醸造試験の様子を研究員解説つきで紹介。
2. 菩提樹から分離された「17株」の酵母
分離・培養で取得した17株の菌株から、優良株を選抜中。プロセスを資料で解説。
3. 歴史と研究が交差するストーリー
なぜ菩提樹の酵母なのか。“進化”を選んだ理由と、100年先を見据えた挑戦をプロジェクトリーダーが語ります。
4. 未来を語る意見交換
見学の最後には、皆さんが感じたことやアイデアをぜひお聞かせください。あなたの声が、次の一歩のヒントになるかも・・・
開催概要
| 日時 | 2026年2月14日 14:00〜16:00 |
| 場所 | 滋賀県工業技術総合センター 別館(滋賀県栗東市上砥山232) |
| 主催 | 百済寺樽プロジェクト(合同会社グリーンラボラトリー) |
| 共催 | 喜多酒造株式会社、滋賀県工業技術総合センター |
| 内容 | 研究解説/有望株解説/施設見学/百済寺樽試飲 |
| 参加枠 | 一般公募 限定3名 (+関係者・たる部等) |
| 注意 | 花酵母を用いた酒の試飲は現段階では行いません。 |
研究現場の見学は、衛生管理・安全面の観点から通常は受入しておりません。今回特別公開となります。
百済寺樽プロジェクトとは
百済寺樽は、室町時代に滋賀・百済寺で醸され、史料にも記され幕府や朝廷に献上された銘酒。しかし1573年の焼き討ちで途絶え、「幻の酒」に。
百済寺樽プロジェクトは2016年に始まり、寺院・酒蔵・地元農家・JA・行政・地域住民などと連携し、“歴史の再現”ではなく、現代に愛され続ける第二の百済寺樽を目指して取り組んでいます。
参加までの流れ
応募フォーム
よくある質問
Q. 参加費はかかりますか?
A.無料です
Q. アルコールが飲めない場合でも参加できますか?
A.はい参加できます
Q. 写真撮影は可能ですか?
A.撮影不可の場所が一部ありますので事前にご案内します
Q. 花酵母のお酒は飲めますか?
A.研究中の菩提樹酵母については試飲なしですが、百済寺樽は試飲があります
Q. 抽選結果はいつ届きますか?
A.2/6(金)です
Q. アクセス/駐車場は?
A.駐車場はございますが、試飲される方は運転はお控えください
お問い合わせ
E-Mail:hyakusaiji.ricewine.pj@gmail.com 百済寺樽プロジェクト事務局
![僧坊酒[百済寺樽]](https://hyakusaijitaru.com/wp-content/uploads/2020/05/cropped-ロゴ文字のみ.png)









のコピー-485x298.png)




